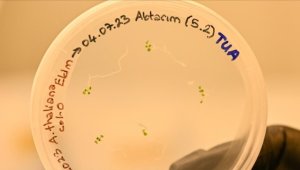
Türk bilim insanları uzayda bitki yetiştirecek

Dürüst Haber Haberleri
Dürüst Haber


18 Ağustos 2023 - 13:42
Büyükkılıç: "Kayseri'miz Bu Modeli İle Yine Örnek Teşkil Edecek"
18 Ağustos 2023 - 13:41
Türk bilim insanları uzayda bitki yetiştirecek 
18 Ağustos 2023 - 08:55
Kayseri'de evinde Hint keneviri yetiştiren kişi yakalandı 
18 Ağustos 2023 - 08:55
Yukatel Adana Demirspor, Osijek'e 3-2 yenilmesine rağmen play-off turuna yükseldi 
18 Ağustos 2023 - 08:55
Beşiktaş adını play-off turuna yazdırdı 
18 Ağustos 2023 - 00:03
Fenerbahçe olaylı maçta Maribor'u farklı yenerek turu aldı 
18 Ağustos 2023 - 00:02
Adıyaman'da 4,1 büyüklüğünde deprem 
18 Ağustos 2023 - 00:02
Çankırı'daki trafik kazasında 1 kişi öldü, 2 kişi yaralandı 
18 Ağustos 2023 - 00:02
Ankara'da rüzgarın etkisiyle devrilen ağaç park halindeki otomobile zarar verdi 
18 Ağustos 2023 - 00:01
Yollardaki Togg sayısı 2 bini aştı 
17 Ağustos 2023 - 23:57
Özhaseki: “Haftaya Kayserispor’un Transfer tahtası açılmış olacak" 
17 Ağustos 2023 - 23:56
TFF Kayserispor’un Fenerbahçe'ye 79 bin Euro daha ödemesine karar verdi